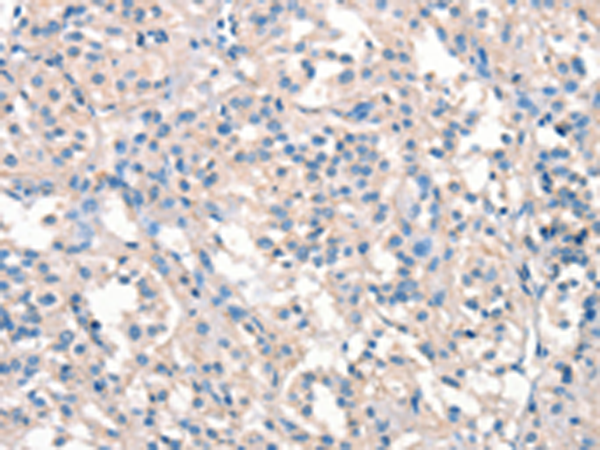

-
分类: 科研抗体货号: P11511别名: p55; p55-GAMMA应用: WB,IHC反应种属: Human, Mouse, Rat
-
分类: 科研抗体货号: P11482别名: DO; DOK1; ARTC4; CD297应用: WB,IHC反应种属: Human
-
分类: 科研抗体货号: P11509别名: EK4; ETK; HEK; ETK1; HEK4; TYRO4应用: WB反应种属: Human, Mouse, Rat
-
分类: 科研抗体货号: P11481别名: GTRAP48; PDZ-RHOGEF应用: WB,IHC反应种属: Human, Mouse, Rat
-
分类: 科研抗体货号: P11501别名: KLA; HFTC3应用: WB反应种属: Human, Mouse, Rat
-
分类: 科研抗体货号: P11479别名: ARH3; ADPRHL2; CONDSIAS应用: IHC反应种属: Human, Mouse
-
分类: 科研抗体货号: P11499别名: HKE2; KE-2; PFD6; H2-KE2应用: WB,IHC反应种属: Human, Mouse
-
分类: 科研抗体货号: P11517别名:应用: IHC反应种属: Human
-
分类: 科研抗体货号: P11498别名: PKCC; PKCG; SCA14; PKC-gamma应用: WB反应种属: Human, Mouse, Rat
-
分类: 科研抗体货号: P11516别名: NRK2; STK2; pp12301应用: IHC反应种属: Human, Mouse

鄂公网安备42018502007531号
鄂公网安备42018502007531号

